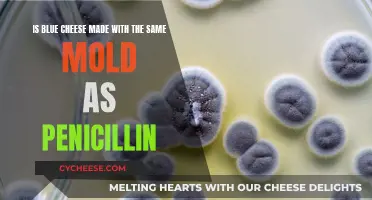
Blue Cheese and Penicillin: A Moldy Connection

Blue cheese is a popular variety of cheese with a distinct flavour and appearance. It is often used in recipes and as a topping for salads and pasta dishes. While blue cheese is generally well-liked, some people may be concerned about its potential impact on health, specifically regarding its purine content. Purines are substances that can be broken down into uric acid, and high levels of uric acid are associated with gout, a type of arthritis that causes inflammation and pain in the joints. So, is blue cheese high in purines, and what does this mean for those who enjoy it?
| Characteristics | Values |
|---|---|
| Blue cheese high in purines | While some sources claim that blue cheese is high in purines, others suggest that there is no evidence to support this claim and that cheese is generally considered lower in purines compared to other protein sources. |
| Gout risk | Blue cheese is associated with an increased risk of gout due to its high content of AMP and IMP, which are broken down into uric acid. However, the recommendation is to consume in moderation rather than abstinence. |
| Alternatives | Lower-purine cheeses like Ricotta, Fresh Chèvre, Cottage Cheese, and Cream Cheese are recommended for individuals with gout. |
Explore related products
What You'll Learn

Blue cheese is not high in purines
Purines are broken down into uric acid in the body, and when the level of uric acid exceeds the body's ability to eliminate it efficiently, it crystallises, leading to inflammation and pain in the joints. While this most commonly affects the big toe, it can also impact other joints such as the ankles, knees, fingers, wrists, and elbows.
It is worth noting that blue cheese, like other cheeses, contains saturated fat, and an increased intake of saturated fat is associated with higher purine metabolism in the body. Therefore, while blue cheese may not be high in purines, it can still influence purine levels in the body through its saturated fat content.
Additionally, blue cheese is rich in yeast, specifically AMP and IMP, which are broken down into uric acid and can increase the risk of gout attacks. However, the recommendation for individuals with gout is not abstinence from blue cheese but rather moderation in consumption.
In conclusion, while blue cheese has been associated with gout due to its saturated fat and yeast content, it is not high in purines. Individuals with gout can make informed dietary choices by understanding the nutritional composition of blue cheese and its potential impact on purine levels and gout risk.
Blue Cheese and FODMAP: What's the Lowdown?
You may want to see also

Blue cheese is safe for gout sufferers in moderation
Blue cheese is a popular variety of cheese with a distinct flavour and appearance. It is a type of cheese that is often mentioned in discussions about gout, a form of arthritis caused by a buildup of uric acid crystals in the joints. While blue cheese does contain some purines, the compound that can trigger gout attacks, it is important to understand that not all cheeses are equal in their impact on the condition.
Firstly, it is worth noting that blue cheese is generally considered lower in purines compared to other protein sources. In fact, cheese as a whole is often considered a gout-friendly food choice when compared to high-purine foods. This is because cheese typically contains lower levels of purines than other options, such as organ meats, seafood, and certain types of meat.
However, when it comes to blue cheese specifically, there are a few considerations to keep in mind. Blue cheese gets its distinctive colour from the presence of yeast, which is a source of AMP and IMP, the specific compounds that contribute to the umami flavour associated with blue cheese. These compounds, AMP and IMP, are also what increase the risk of gout attacks. Therefore, while blue cheese may be lower in purines overall, the presence of these specific compounds means it could still potentially trigger gout attacks.
Additionally, the fat content of blue cheese can be a factor in gout management. High-fat cheeses can influence purine metabolism in the body, and blue cheeses tend to be creamier and higher in fat. As a result, it is generally recommended that gout sufferers opt for lower-fat, lower-purine cheeses, such as ricotta, fresh chèvre, cottage cheese, and cream cheese. However, this does not mean that blue cheese is entirely off the menu for gout sufferers.
Blue cheese can still be enjoyed by gout sufferers, but in moderation. Gout management often involves monitoring and limiting the intake of certain trigger foods, rather than completely abstaining from them. This means that gout sufferers can still include blue cheese as part of a balanced diet, as long as it is not consumed in excessive quantities. Additionally, combining blue cheese with other gout-friendly foods, such as coffee and water, can help to offset its potential negative effects.
Blue Cheese and Pinot Noir: A Match Made in Heaven?
You may want to see also

Blue cheese is high in saturated fat
Blue cheese is often considered to be high in saturated fat, and while it does contain some purines, it is generally considered lower in purines compared to other protein sources. Blue cheese gets its distinctive colour from the yeast that is rich in AMP and IMP, which are purine-rich substances. These substances are broken down into uric acid, which can lead to gout. However, it is important to note that not all purine-rich foods trigger gout attacks, and blue cheese has much lower levels of purines compared to organ meats and seafood.
Cheese, in general, is a source of concern for people with gout, a type of arthritis caused by the buildup of uric acid crystals in the joints. Gout sufferers are often advised to monitor their intake of saturated fats, as they can influence purine metabolism in the body. High-fat intake is associated with increased purine metabolism into uric acid, and certain cheeses that are very high in saturated fats, such as creamy blue cheeses, can be problematic for gout sufferers.
However, not all blue cheeses are created equal in terms of their fat content and potential impact on gout. Fresh cheeses, such as cottage cheese, cream cheese, and ricotta, are typically lower in fat and purines compared to their aged counterparts. These low-fat cheeses can be safely enjoyed in moderation by gout sufferers without the same risk of triggering gout attacks.
While blue cheese may be higher in saturated fat than some other cheeses, it is important to note that there is no conclusive evidence to suggest that blue cheese specifically contains higher purine levels. In fact, some sources suggest that dairy products, including cheese, may be associated with a reduced risk of gout in some individuals. Therefore, while blue cheese may be high in saturated fat, its impact on gout may be influenced by various factors, and it may not necessarily be a trigger for everyone.
Blue Cheese: Fridge Storage and Shelf Life
You may want to see also
Explore related products

Blue cheese is rich in yeast
Gout is a form of arthritis caused by a buildup of uric acid crystals in the joints, leading to inflammation and intense pain. While it most commonly affects the big toe, gout can also impact other joints such as the ankles, knees, fingers, wrists, and elbows. People with gout are often advised to monitor their diet, as certain foods can trigger gout attacks or worsen the condition.
Blue cheese, specifically creamy varieties, is considered a high-purine food due to its yeast content. However, it is important to note that not all sources agree on the purine levels in blue cheese. Some suggest that blue cheese is lower in purines compared to other protein sources and that its impact on gout may be overstated.
For individuals concerned about gout, it is recommended to consume blue cheese in moderation rather than abstaining completely. Additionally, opting for lower-purine cheeses, such as ricotta, fresh chèvre, cottage cheese, or cream cheese, can be a suitable alternative. These fresh cheeses tend to have milder flavours and creamier textures, making them versatile additions to various dishes.
While managing gout, it is also advisable to limit the intake of foods high in saturated fats, as they can influence purine metabolism. This includes fatty meats, full-fat cheeses, butter, and certain processed foods. Striking a balance in protein consumption is crucial, as excessive protein intake can lead to increased purine synthesis in the body.
Blue Cheese Heartburn: Is It a Real Concern?
You may want to see also

Blue cheese is a source of umami
The umami flavour is particularly enhanced in cured, smoked, dried, aged, boiled, or cooked meat, making gravies and rich sauces excellent sources of umami. Other foods that are sources of umami include organ meats, shellfish, anchovies, and beer. While these foods can increase the risk of gout, the recommendation is not abstinence but rather moderation.
Blue cheese, specifically creamy varieties, can be problematic for gout sufferers due to their high saturated fat content, which may influence purine metabolism in the body. However, not all blue cheeses pose a threat to those with gout, and some may even be safely enjoyed in moderation. For example, gorgonzola cheese, a type of blue cheese, is rich in yeast and may increase the risk of a gout attack. On the other hand, fresh cheeses like cottage cheese, cream cheese, and ricotta are lower in purines and can be good alternatives for those concerned about gout.
It is worth noting that there is evidence suggesting that dairy products, including cheese, may be associated with a reduced risk of gout in some individuals. Additionally, meat protein seems to be more of a concern than milk and milk-derived products when it comes to gout. Therefore, while blue cheese can be a source of umami and may contribute to gout risk, it is important to consider the overall diet and consume it in moderation as part of a balanced diet.
Blue Cheese Dressing: Is That Mold?
You may want to see also
Frequently asked questions
Blue cheese is considered to be high in purines, especially when compared to other cheeses. Blue cheese is also rich in yeast, which may increase the risk of a gout attack.
Purines are substances that are broken down into uric acid. When the level of uric acid exceeds the body's ability to eliminate it, it crystallizes, leading to inflammation and intense pain in the joints.
Organ meats such as liver, processed red meats, shellfish, anchovies, mackerel, herring, and beer are all high in purines.
Lower-purine cheeses include Ricotta, Fresh Chèvre, Cottage Cheese, and Cream Cheese.